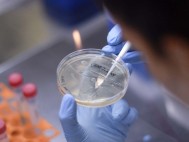

|
Efemerides.-
27 de marzo |
| 1847. El puerto de Veracruz capitula ante las fuerzas invasoras norteamericanas al mando del general Winfield Scott. 2020-03-26 22:36:49 |
 |

|
Estatal.-
Descartan vacío de poder en Actopan, y sin embargo, como decía Galileo
nadie sabe dónde andan tesorera y alcalde prófugo |
| No obstante, la diputada local de Morena confirmó que la síndica suplente, Nayeli Toral Ruíz, no ha asumido el cargo pese a que sí expresó su intención al C... 2020-03-26 22:35:12 |
 |

|
Estatal.-
Designan a Naldy Patricia Comisionada del IVAI con amplia calidad académica y trayectoria; su antecesora a la cárcel |
| La comisionada recién designada sustituyó en el cargo a Yolli García Álvarez quien formalmente concluyó su cargo este día, aunque se fue en medio de denun... 2020-03-26 21:47:43 |
 |

|
Estatal.-
Denuncian aumento injustificado de precios en Veracruz |
| Bruno Rodrigo Fajardo Sánchez, delegado de la Procuraduría Federal del Consumidor, informó que se han elevado las quejas por incremento injustificado en pre... 2020-03-26 21:24:14 |
 |

|
Finanzas.-
JP Morgan prevé contracción de 7% en crecimiento de México |
| La previsión de la institución financiera parte de que el país no ha pasado a una fase de contagio masivo, y cuando ésta llegue, el impacto en la economía i... 2020-03-26 21:22:55 |
 |

|
Nacional.-
Senado no despedirá a empleados durante contingencia por Covid-19 |
| La Mesa Directiva del Senado aprobó un acuerdo para continuar algunas labores mientras dure la contingencia por el coronavirus
2020-03-26 21:21:05 |
 |

|
Finanzas.-
Plan para enfrentar crisis por Covid-19 implica un costo de hasta 581 mmdp: CIEP |
| Lo anterior implicaría un costo de entre 1.3 y 2.2 por ciento del Producto Interno Bruto (PIB), según el estudio Consideraciones de política fiscal ante el... 2020-03-26 21:19:46 |
 |

|
Mundo.-
Uruguay rebajará salarios públicos y pensiones por coronavirus |
| Uruguay anunció este jueves una rebaja por dos meses de jubilaciones y salarios de funcionarios públicos para la creación de un fondo dirigido a cubrir los ... 2020-03-26 21:17:52 |
 |

|
Sociedad.-
Que Dios los bendiga y todo esté bien, dice abuelito al recibir apoyo |
| Una pizzería de León regala pizza y refresco a personas de la tercera edad durante la contingencia por coronavirus
2020-03-26 21:16:11 |
 |

|
Nacional.-
¡Cuidado! Venden en Facebook falsa prueba para detectar Covid-19 |
| La SSC informó que se trata de un fraude, y hasta ahora la venta de medicamentos en redes sociales no está permitida
2020-03-26 21:14:39 |
 |

|
Nacional.-
En Edomex y Michoacán reportan primeras muertes por COVID-19. No están en la lista de los 8 de Salud |
| Los casos positivos aumentaron a 585 en el país hoy en México. También hay en el país 2 mil 156 casos sospechosos y 2 mil 965 negativos, informaron autorida... 2020-03-26 21:12:28 |
 |

|
Nacional.-
30% de restaurantes en México están cerrados por COVID-19, un hecho nunca antes visto: Canirac |
| La asociación de restauranteros llamó a fortalecer toda la cadena productiva para que, solidariamente, las acciones que se tomen minimicen en lo posible su ... 2020-03-26 21:11:07 |
 |
|
Cartas a la redacción.-
Sospechosos o infectados de COVID-19 en la SEDARPA |
| 2020-03-26 21:10:12 |
 |

|
Nacional.-
Si eres mujer, sufres violencia y estás en casa llama a Locatel o al 911, piden Sheinbaum e Inmujeres |
| El Inmujeres y el Gobierno de la Ciudad de México han reiterado que la contingencia por el COVID-19 no limitará la atención a la violencia contra mujeres, p... 2020-03-26 21:08:39 |
 |

|
Nacional.-
Adjudicó y firmó CEAV contratos por más de 43 mdp a finales de 2019 |
| A través de un boletín, la dirección de prensa de la CEAV señaló este jueves que se trata de 12 contratos por 43 millones 412 mil 415.62 pesos, de los cuale... 2020-03-26 19:46:53 |
 |

|
Finanzas.-
Se avecina "grave" situación económica por Covid-19: académico |
| El especialista en desarrollo económico reconoció el trabajo de las autoridades de salud, pero advirtió también que se agravará la economía informal por las... 2020-03-26 19:46:11 |
 |

|
Policiaca.-
Asesinan a mujer en calles de Tlalpan |
| Los primeros reportes policiacos refieren que el automóvil Volkswagen clásico, con placas MZA-42-55, tiene por lo menos tres impactos de arma de fuego en la... 2020-03-26 19:45:20 |
 |

|
Nacional.-
Profeco lanza advertencia a 26 empresas por aumentos injustificados |
| La dependencia dijo que las empresas tienen cuatro horas para actuar, de lo contrario van a proceder en consecuencia mediante multas
2020-03-26 19:43:02 |
 |

|
Nacional.-
Pese a Covid-19, Secretaría de Bienestar mantiene labores estratégicas |
| La dependencia adopta las medidas sanitarias necesarias para el funcionamiento de las áreas indispensables para la entrega de los Programas Integrales de Bi... 2020-03-26 19:40:50 |
 |

|
Nacional.-
Los efectos del coronavirus en el campo de Guerrero |
| En comunidades rurales ya son visibles los estragos para los campesinos de Guerrero. Productos como Maíz y Jitomate se están rezagando porque en las ciudade... 2020-03-26 19:39:55 |
 |
|
Mundo.-
Australia probará vacuna de tuberculosis contra coronavirus |
| Un grupo de científicos anunció que probará si la vacuna contra la tuberculosis es efectiva contra el coronavirus
2020-03-26 19:38:58 |
 |

|
Nacional.-
Sánchez Cordero envía mensaje de unión a la población mexicana ante Covid-19 |
| A través de su cuenta de Twitter la subsecretaria de Gobernación envió un mensaje de aliento y unión a la población en México ante la cuarentena por coronav... 2020-03-26 19:38:08 |
 |

|
Nacional.-
Suben a 585 los casos positivos de Covid-19 en México |
| La Secretaría de Salud federal también informó que el número de casos sospechosos de la nueva cepa de coronavirus se ubica en 2156
2020-03-26 19:36:08 |
 |

|
Nacional.-
Confirman ocho muertos por coronavirus en México |
| Ana Lucía de la Garza, directora de Investigación Operativa Epidemiológica, detalla que el número de casos confirmados de Covid-19 se coloca en 585
2020-03-26 19:34:58 |
 |

|
Mundo.-
G20 promete dinero, esfuerzo y valentía contra COVID-19, pero ONU prevé una crisis peor que en 2008 |
| Algunos líderes pidieron treguas y moratorias a medidas que pueden entorpecer el comercio actual, el Presidente de México, Andrés Manuel López Obrador, tamb... 2020-03-26 19:28:24 |
 |

|
Mundo.-
Miles de latinoamericanos están regados por el mundo; gobiernos buscan, desesperados, traerlos |
| Casi al mismo tiempo que se decretó la pandemia por la Organización Mundial de la Salud, el británico Scott Lambert, de 36 años, voló a Brasil y desde hace ... 2020-03-26 19:26:54 |
 |

|
Nacional.-
COVID-19: Mexicanos ponen condiciones para dejar pasar a estadounidenses por la frontera |
| Habitantes del estado de Arizona en cuarentena han optado por dejarla a un lado y están cruzando la frontera
2020-03-26 18:38:34 |
 |

|
Deportes.-
¡3 años
y despierta del coma! Jugador del Ajax sufrió daños cerebrales |
| El futbolista Abdelhak Nouri dio la enorme noticia durante este jueves después de 32 meses que pasó en coma tras un choque en un partido
2020-03-26 18:37:30 |
 |

|
Nacional.-
Estado de México reporta primer fallecido por COVID-19 |
| El fallecimiento ocurrió en el Hospital Regional de Alta Especialidad de Ixtapaluca, donde el paciente ingresó desde el pasado 22 de marzo
2020-03-26 18:36:39 |
 |

|
Nacional.-
Aumentan a 97 los casos positivos de Covid-19 en NL |
| La Secretaría de Salud de Nuevo León informó que a partir de este jueves manejarán también los casos confirmados en los hospitales privados
2020-03-26 18:34:52 |
 |

|
Sociedad.-
Así debes limpiar tu hogar ante pandemia por Covid-19, según EU |
| Por lo anterior, los Centros para el Control y la Prevención de Enfermedades de Estados Unidos (CDC por sus siglas en inglés), dieron algunas recomendacione... 2020-03-26 18:33:49 |
 |

|
Nacional.-
Tijuana declara emergencia sanitaria por Covid-19 |
| El presidente municipal de Tijuana, Arturo González Cruz, firmó la declaratoria de riesgo sanitario en la ciudad por el coronavirus
2020-03-26 18:32:57 |
 |

|
Nacional.-
Establecen toque de queda en Jonuta, Tabasco, por Covid-19 |
| El Ayuntamiento también restringió el ingreso de camiones de transporte provenientes de Chiapas y Campeche
2020-03-26 18:31:51 |
 |

|
Mundo.-
Se registra sismo de magnitud 5 en Texas; se sintió en Chihuahua |
| El sismo se sintió en algunas regiones del estado de Chihuahua; no se reportan afectaciones.
2020-03-26 18:30:24 |
 |

|
Nacional.-
Así improvisa enfermera en México careta con botellas Pet |
| Lourdes Rodríguez indicó que esta herramienta permite que sus compañeras se protejan de contagios al atender a los pacientes
2020-03-26 18:28:08 |
 |

|
Sociedad.-
Pelaje de mascotas no transmite Covid-19, aclaran |
| Estudios científicos demuestran que superficies suaves y lisas transmiten el virus de manera más eficiente que las superficies fibrosas y porosas como el pe... 2020-03-26 18:26:42 |
 |

|
Mundo.-
Venezuela registra su primer fallecido por el coronavirus |
| Nicolás Maduro informó este jueves sobre la primera muerte por el coronavirus registrada en Venezuela
2020-03-26 18:25:24 |
 |

|
Nacional.-
Piden protocolos para cádaveres de personas con Covid-19 |
| Gabriela Quiroga urgió a implementar mecanismos para proteger a trabajadores de funerarias y familiares de los fallecidos
2020-03-26 18:23:51 |
 |

|
Nacional.-
Choque de tractocamiones deja un muerto en Ecatepec |
| Un tráiler se impactó contra la parte trasera de otro vehículo, lo que provocó que se incendiara sobre el Circuito Exterior Mexiquense
2020-03-26 18:18:55 |
 |

|
Espectáculos .-
Actor de 'You' muere por complicaciones a causa del coronavirus |
| El actor estadunidense Mark Blum falleció esta semana a los 69 años debido a complicaciones derivadas del Covid-19
2020-03-26 18:17:30 |
 |

|
Tecnología.-
Huawei presentó los P40, los celulares de las fotos perfectas |
| Integrada por tres equipos, los nuevos P40, P40 Pro y P40 Pro+ siguen una línea de diseños muy hermosos, innovación y cámaras ultra poderosas
2020-03-26 18:15:07 |
 |

|
Nacional.-
Cyhthia llegó a hospital en Tamaulipas. Dijo que había abortado y mostró el cuerpo de una bebé. Mentía |
| Jessica, la mujer que fue asesinada por Cyhthia Fátima S, fue reportada como desaparecida el 27 de marzo de 2018. En ese momento tenía 8 meses de embarazo... 2020-03-26 18:10:05 |
 |

|
Nacional.-
El COVID-19 pone a AMLO en el ojo internacional: Expertos analizan aciertos y errores de su estrategia |
| Durante su participación en la cumbre, López Obrador pidió a las grandes potencias una tregua comercial y financiera para no afectar a los desfavorecido... 2020-03-26 18:08:55 |
 |

|
Nacional.-
La Guardia Nacional, apuesta de AMLO para detener la violencia, cumple 1 año sin dar resultados |
| Andrés Manuel López Obrador ha puesto la nueva Guardia Nacional en el centro de su política de seguridad, aunque poco a poco ha ido aplazando la fecha previ... 2020-03-26 18:07:42 |
 |

|
Nacional.-
Amcham pide estrategia a gobierno mexicano para mitigar Covid-19 |
| El organismo que agremia empresas de Estados Unidos y mexicanas, reconoció la instalación del Consejo de Salubridad General, pero sugirió a la actual admini... 2020-03-26 16:57:11 |
 |

|
Nacional.-
Procesan a tres por torturar a detenido en caso Ayotzinapa |
| La Fiscalía General de la República (FGR) informó que la Unidad Especial de Investigación y Litigación para el caso Ayotzinapa, obtuvo la resolución judicia... 2020-03-26 16:55:59 |
 |

|
Policiaca.-
Asesinan a cuatro mujeres en Tijuana en las últimas 24 horas |
| Según la Agencia Estatal de Seguridad e Investigación la mujer, de alrededor 40 años de edad, fue herida por un objeto contuso.
2020-03-26 16:55:17 |
 |

|
Mundo.-
Fiscalía venezolana abre proceso a Juan Guaidó |
| La apertura del proceso fue anunciada por el fiscal general, Tarek William Saab, quien indicó en su cuenta de Twitter que abrió el proceso a Guaidó, al mayo... 2020-03-26 16:54:28 |
 |

|
Mundo.-
Asesinan en Colombia a lideresa social |
| El crimen se produjo el martes en el municipio de San Pablo. Hombres armados irrumpieron en su casa y la obligaron a salir y caminar unos metros antes de ma... 2020-03-26 16:53:44 |
 |

|
Mundo.-
Reino Unido registra 115 muertos en un día, 578 en total |
| A las 17H00 GMT "578 pacientes en el Reino Unido que dieron positivo por coronavirus han muerto", frente a los 463 del día anterior, informó el sitio intern... 2020-03-26 16:52:50 |
 |

|
Nacional.-
UIF pide documentar hechos que retrasen reportes de lavado de dinero |
| Lo anterior, a fin de que en su caso se presente el programa de autocorrección respectivo ante la CNBV y, adicionalmente, cualquier reporte de operaciones q... 2020-03-26 16:51:58 |
 |

|
Nacional.-
Si se cumple confinamiento se podrá enfrentar mejor la fase 3: López-Gatell |
| Durante la conferencia matutina aseveró que las medidas restrictivas a la movilidad podrían ser más extremas pero en un país con una alta desigualdad social... 2020-03-26 16:51:04 |
 |

|
Nacional.-
Con actos vandálicos, piden destitución de titular de Conagua en Chihuahua |
| Productores agrícolas protestaron este jueves por la apertura de compuertas de la presa La Boquilla
2020-03-26 16:47:42 |
 |

|
Sociedad.-
¿Qué hacer si pierdo el pasaporte en otro país? |
| Si por alguna razón perdiste o te robaron el pasaporte es necesario que sigas ciertos pasos para poder regresar a México sin problema alguno
2020-03-26 16:46:07 |
 |

|
Nacional.-
Auto-transportistas de carga acusan abandono de autoridades |
| La Canacar propuso un Programa Emergente para garantizar el abasto, enfrentar la emergencia sanitaria y salvaguardar los empleos
2020-03-26 16:44:55 |
 |

|
Nacional.-
ISSSTE suspende trámites de préstamos personales por Covid-19 |
| El Instituto de Seguridad y Servicios Sociales de los Trabajadores del Estado informó que los Formatos de Solicitud de Préstamos Personal 2020, son vigentes... 2020-03-26 16:43:54 |
 |

|
Nacional.-
Red ECOs coadyuva para enfrentar Covid-19 |
| Integrada por instituciones de educación superior, institutos de salud, centros de investigación y distintos organismos busca contribuir a la solución del c... 2020-03-26 16:42:54 |
 |

|
Nacional.-
El Gobierno mimó a la chatarra por años. Hoy, el COVID-19 ataca a un México de obesos y diabéticos |
| Ante la falta de políticas públicas contra la expansión de la industria de la chatarra, México enfrenta el COVID-19 con otras dos epidemias: 96 millones de ... 2020-03-26 16:39:20 |
 |

|
Mundo.-
Más de medio millón infectados y más de 23 mil muertos dicen que la epidemia no camina hacia mejor |
| Más de medio millón de casos de contagio se registran tan sólo dos semanas después de que la Organización Mundial de la Salud (OMS) confirmara 118 mil casos... 2020-03-26 16:37:37 |
 |

|
Nacional.-
El coronavirus somete al mundo a una recesión económica que no hemos visto, quizás, nunca antes |
| Pese al escenario adverso, la OMC, el FMI y el BM han señalado que la solidaridad entre los países será vital para afrontar el actual escenario de incertidu... 2020-03-26 16:35:49 |
 |

|
Finanzas.-
Standard & Poors baja la deuda soberana de México de BBB+ a BBB por COVID-19 y caída del petróleo |
| La baja en los precios del petróleo y los impactos económicos que deje el coronavirus sobre la economía nacional y la de EU impactaron la perspectiva de la ... 2020-03-26 16:33:02 |
 |

|
Mundo.-
Estados Unidos, vecino de México, supera a China e Italia en casos de COVID-19, informan Reuters y NYT |
| En la nación norteamericana han sido confirmados más de 81 mil casos positivos de COVID-19, de acuerdo con el diario New York Times y la agencia Reuters.
... 2020-03-26 16:32:08 |
 |

|
Espectáculos .-
La actriz Camila Sodi confirma que ella y su hija dieron positivo en prueba por COVID-19 |
| Sodi, sobrina de la cantante Thalia, compartió algunas recomendaciones a sus seguidores como quedarse en casa si presentas síntomas leves, esto con la final... 2020-03-26 16:30:26 |
 |

|
Cultura.-
Red de teatros prevé pérdida de unos $10 millones por Covid-19 |
| 2020-03-26 15:06:17 |
 |

|
Nacional.-
Conagua comienza extracción de agua de La Boquilla para EU |
| La Comisión Nacional del Agua (Conagua) comenzó a extraer desde ayer por la noche 110 metros cúbicos por segundo de la presa La Boquilla, ubicada en Chihuah... 2020-03-26 15:00:22 |
 |

|
Policiaca.-
Asesinan a 14 en Guanajuato; encuentran restos en bolsas |
| En el estado de Guanajuato fueron asesinadas 14 personas, se encontraron bolsas con restos humanos y un cuerpo en proceso de descomposición, informó la Fisc... 2020-03-26 14:57:32 |
 |

|
Nacional.-
Segob invita a medios y población no difundir información falsa sobre Covid-19 |
| El subsecretario Ricardo Peralta indicó que con esta medida no se atenta contra la libertad de expresión
2020-03-26 14:50:47 |
 |

|
Mundo.-
Reportan caída de internet en el mundo; Google y otros servicios se vieron afectados |
| A través del servicio DownDetector, reportan caída en internet de múltiples servicios e importantes aplicaciones de entretenimiento y trabajo
2020-03-26 14:45:50 |
 |

|
Álamo Temapache .-
En la Fase dos, indispensable resguardarse en casa y extremar medidas de higiene: alcalde de Álamo Jorge Vera Hernández |
| 2020-03-26 14:45:30 |
 |

|
Nacional.-
En 4 días, detienen a 73 durante 30 robos e intentos de saqueos en CDMX |
| Desde el 23 de marzo, en la Ciudad de México han sido detenidas 73 personas por robos o intentos de saqueos
2020-03-26 14:36:29 |
 |

|
Nacional.-
Primer muerto por Covid-19 en Quintana Roo |
| Alejandra Aguirre, secretaria de Salud de Quintana Roo confirmó la muerte la octava muerte por Covid-19 en México
2020-03-26 14:31:58 |
 |

|
Nacional.-
Edomex suma 42 casos positivos de COVID-19 |
| La Secretaría de Salud del Estado de México exhorta a seguir las redes sociales oficiales a fin de obtener información
2020-03-26 14:28:17 |
 |

|
Sociedad.-
Coronavirus: Consecuencias económicas y sociales de la pandemia |
| La crisis mundial por COVID-19 no solo tiene afectaciones sanitarias, también marcará un antes y un después en la economía y la sociedad
2020-03-26 14:25:55 |
 |

|
Policiaca.-
Aseguran en Tamaulipas 270 mil litros de combustible |
| Las autoridades estatales detectaron irregularidades y falta de documentación que acreditara su legal introducción al país
2020-03-26 14:07:01 |
 |

|
Mundo.-
Petróleo, otra vez a la baja; cae a 22.60 dólares en NY |
| El precio del barril de petróleo volvió a caer este jueves en Nueva York luego de tres jornadas consecutivas de alzas, cuando los datos de desempleo en Est... 2020-03-26 13:36:45 |
 |

|
Nacional.-
Banxico recomienda lavarse las manos después de tocar billetes y monedas |
| El Banco de México (Banxico) garantiza la continuidad de operaciones y la adecuada distribución de efectivo
2020-03-26 13:25:12 |
 |

|
Nacional.-
Suman 44 personas las contagiadas por Covid-19 en Puebla |
| La epidemia ya se extendió a siete, principalmente la capital Puebla
2020-03-26 13:22:34 |
 |

|
Nacional.-
Covid-19 ha destapado la descoordinación entre gobiernos estatales y federal para atender la emergencia |
| Aunque el presidente ha instado a no realizar pruebas masivas, gobiernos estatales no han seguido las recomendaciones
2020-03-26 13:19:01 |
 |

|
Nacional.-
Mapa del coronavirus en México: ya son siete muertos, 475 positivos y los sospechosos se disparan |
| Actualmente hay 1,656 personas que pudieran estar contagiadas; la CDMX y puebla aumentaron 16 y 12casos en 24 horas
2020-03-26 13:15:25 |
 |

|
Mundo.-
Sismo de magnitud 6.1 golpea Filipinas |
| Hasta el momento las autoridades de Filipinas no han informado sobre posibles víctimas o daños mayores por el sismo
2020-03-26 13:08:05 |
 |

|
Nacional.-
Quedan varados en Honduras 66 misioneros mexicanos por pandemia |
| Los mexicanos se quedaron varados debido a la cancelación de vuelos y cierre de fronteras
2020-03-26 13:01:09 |
 |

|
Nacional.-
Con una gotita de sangre sabrás si tienes COVID-19. Ya llegaron las pruebas rápidas a Jalisco |
| Son 20 mil las pruebas para detección de coronavirus en solo 15 minutos
2020-03-26 12:58:18 |
 |

|
Nacional.-
Confirman cuatro nuevos casos de Covid 19 en Aguascalientes |
| 2020-03-26 12:23:27 |
 |

|
Nacional.-
Sismo sorprende habitantes de Ciudad Juárez; descartan alerta de tsunami |
| El temblor, de intensidad 5.0, se registró a las 9:16 de la mañana con epicentro en Mentone, Texas
2020-03-26 12:20:02 |
 |

|
Mundo.-
Muertes en Nueva York por coronavirus suben a 385, 100 en un solo día |
| El gobernador de Nueva York, Andrew Cuomo, anunció el jueves que el saldo de muertes del estado debido al coronavirus subió a 385, 100 de ellas en las últim... 2020-03-26 11:15:49 |
 |

|
Nacional.-
Ejecutan a líder del PVEM en QR |
| El ex diputado local por el Partido de la Revolución Democrática, (PRD) y actualmente uno de los principales líderes del Partido Verde Ecologista de México,... 2020-03-26 11:12:56 |
 |

|
Nacional.-
Jefes de Estado deben asumir compromiso común frente a Covid-19: Ebrard |
| El secretario de Relaciones Exteriores, Marcelo Ebrard, afirmó que es cuestión de horas o días para que los jefes de Estado más poderosos del mundo asuman u... 2020-03-26 11:10:30 |
 |

|
Mundo.-
España compró a China 9 mil pruebas imprecisas para detectar Covid-19: Patricia Alvarado |
| La periodista española señaló que muchas de estas pruebas han dado negativo cuando los pacientes bien podrían estar infectados
2020-03-26 11:05:17 |
 |

|
Nacional.-
Economía mexicana tiene su peor inicio de año desde 2009 |
| La contracción de la economía obedeció a una caída de las actividades secundarias y de las actividades terciarias
2020-03-26 11:02:40 |
 |

|
Nacional.-
Desempleo en México crece a niveles no vistos |
| La tasa de desocupación subió a un 3.7%, desde el 3.6% registrado en enero, el nivel más alto desde septiembre de 2016
2020-03-26 11:00:16 |
 |

|
Deportes.-
Real Madrid se une a lucha contra Covid-19: Bernabéu será centro de acopio |
| El Real Madrid facilitará a las entidades y empresas, muy especialmente aquellas vinculadas al deporte, la posibilidad de hacer llegar a este centro las don... 2020-03-26 10:24:10 |
 |

|
Espectáculos .-
Meghan Markle le prohibió al príncipe Harry viajar a Reino Unido para ver a su padre enfermo de coronavirus |
| Alejado de su familia tras renunciar a la corona británica, el duque de Sussex se encuentra en Canadá con su esposa e hijo
2020-03-26 10:11:33 |
 |

|
Nacional.-
Que quede muy claro, Fase 3 del Covid-19 se va a dar en México: López-Gatell |
| "La epidemia no se quita de un día para otro. Tengamos muy claro que eso no se puede lograr", agregó López-Gatell acompañado del presidente
2020-03-26 09:59:32 |
 |

|
Mundo.-
Nicolás Maduro es inculpado por narcoterrorismo por parte de EU |
| Estados Unidos inculpa de "narcoterrorismo" al presidente venezolano Nicolás Maduro
2020-03-26 09:55:52 |
 |

|
Mundo.-
Covid-19: EU dará 4 meses de sueldo a empleados despedidos |
| Donald Trump aseguró que esta medida es parte del mayor programa de apoyo a la población
2020-03-26 09:49:01 |
 |

|
Finanzas.-
Peso y mercados mantienen la fortaleza durante la apertura |
| El peso mantuvo su avance durante la apertura de la jornada con un fortalecimiento de 0.83 por ciento frente al dólar
2020-03-26 09:45:46 |
 |

|
Mundo.-
Tercera Guerra Mundial ya inició, asegura presidente de El Salvador sobre el Covid-19 |
| El presidente de El Salvador, Nayib Bukele, aseguró a través de su cuenta de Twitter que la Tercera Guerra Mundial inició por el Covid-19
2020-03-26 09:44:18 |
 |

|
Nacional.-
Gobierno reduce labores a nivel federal por COVID-19 |
| La medida busca que más personas se queden en casa. Lanzan programa de ayuda a las micro y pequeñas empresas
2020-03-26 09:39:15 |
 |

|
Nacional.-
Jalisco registra segunda muerte por Covid-19; es séptima víctima en México |
| El gobernador del estado confirmó la segunda muerte en el estado, ocurrió durante la madrugada de este jueves
2020-03-26 09:35:18 |
 |

|
Nacional.-
Estos son los temas que planteó AMLO a líderes del G-20 sobre Covid-19 |
| El presidente también pidió a manera de urgencia que la ONU tome el control todo del comercio de medicamentos y equipo médico
2020-03-26 09:30:20 |
 |

